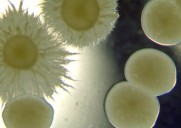
Candida
                      heilt mit Borax weg

ESP
Merkblatt: Heilwirkung von Borax und Bor (Borax-Heilwasser)
Arthritis, Artrose, Gelenkschmerzen, Osteoporose, Krebs, Psoriasis, Rosazeae, Impotenz, Augen, Hirn und Gedächtnis, Candida, Fusspilz, Vaginitis etc.
Das Mineral Borax heilt Arthritis, Artrose, Gelenkschmerzen, Osteoporose, Krebs, Psoriasis, Rosazeae, Impotenz, Augen, Hirn und Gedächtnis, Candida, Fusspilz, Vaginitis etc. -- Bor und seine Funktionen im Körper -- Die Einnahme von Borax -- Die Heilungen mit Borax: Arthritis, Artrose, Gelenkschmerzen, Osteoporose, Krebs, Psoriasis, Rosazeae, Impotenz, Augen, Hirn und Gedächtnis, Candida, Fusspilz, Vaginitis etc. -- Die Heilungszeit mit Borax: 2 Tage bis 3 Monate -- Die kriminell-korrupte EU verbietet Borax im Jahre 2010, um die Gift-Pharama-Industrie zu schützen (!): Die Intrige in Brüssel gegen Borax -- Weltweite Intrige gegen Borax -- Appell: Sich nichts verbieten lassen, was natürlich ist - die Pharma soll endlich auf Naturmedizin umstellen -- Einnahmeplan aus Zürich -- Borax für Gelenke und Zirbeldrüse --

Borax in der Packung [1] - Borax auf dem Teelöffel, die Dosis für 1 Liter Heilwasser [2]
Zum Einnehmen: 1/8 Teelöffel Borax in 1 Liter Wasser mischen - 1 Schluck pro Tag 5 Tage lang - 2 Tage Pause machen - immer so weiter, bis die Schmerzen verschwinden (Informantin Matterhorn am 8.12.2024)
Zum Einreiben: Borax-Pulver und Olivenöl oder ein anderes Öl aus der Küche mischen und einreiben - 1dl Olivenöl mit 2-3 Messerspitzen Boraxpulver (Informantin Matterhorn am 30.1.2025)
von Michael Palomino (2017 / 2024 / 2025)